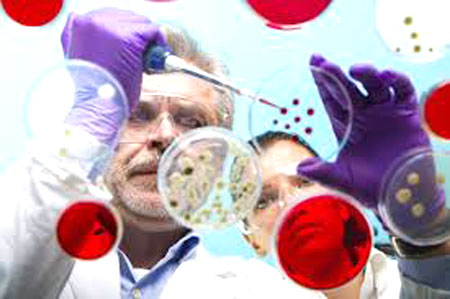

Ngày 22/9/2014. WHO - Mặc dù trong những ngày qua các quốc gia bị ảnh hưởng dịch bệnh Ebola với sự trợ giúp tích cực của Chính phủ Hoa kỳ cùng nhiều tổ chức quốc tế như Liên hợp quốc (UN), Tổ chức Y tế thế giới (WHO), Ngân hàng thế giới (WB), Quỹ Gates (Gates Foundation), Liên minh châu Âu (EU)… nhưng tình hình dịch bệnh càng trở nên tồi tệ khi số ca nhiễm và tử vong không ngừng gia tăng ở khu vực Tây Phi.
Tổ chức Y tế thế giới (WHO) cho biết dịch bệnh Ebola đang hoành hành ở Tây Phi hầu như vẫn ngoài tầm kiểm soát quốc tế khi số ca tử vong và số ca mắc mới liên tục gia tăng, tuy nhiên sự lây lan của virus tử thần bắt đầu được kiềm chế ở Senegal và Nigeria. Theo số liệu thống kê mới nhất của tổ chức này đến ngày 19/9/2014, dịch Ebola đã cướp đi sinh mạng của 2.811 người trong tổng số 5.864 ca nhiễm bệnh, như vậy số ca tử vong tăng thêm 181 chỉ trong vòng 4 ngày (từ 14/9). Trong số 6 quốc gia nằm trong vùng dịch, Liberia hiện đang bị ảnh hưởng nặng nề nhất (3.022 ca mắc và 1.578 tử vong); Guinea (942 ca mắc, 601 tử vong); Sierra Leone (1.673 ca mắc, 562 tử vong); Nigeria (21 ca mắc, 8 tử vong); Senega (1 ca mắc, 0 tử vong) và Cộng hòa dân chủ Công Gô (71 ca mắc, 40 tử vong). Đặc biệt là Senegal đã không phát hiện ca nhiễm mới nào kể từ trường hợp đầu tiên và duy nhất cho tới nay vào ngày 29/8/2014 là một sinh viên người Guinea hiện đã bình phục; Nigeria-nơi có 21 người nhiễm, trong đó có 8 người tử vong, không phát hiện bất kỳ trường hợp mới nào kể từ ngày 8/9/2014.
Mặc dù WHO cho rằng các ổ dịch tại Tây Phi vẫn là một "vấn đề khẩn cấp quốc tế đáng quan ngại trong lĩnh vực y tế cộng đồng" nhưng vẫn phản đối các lệnh cấm đi lại thay vì cần phải có "các biện pháp kiểm soát an ninh phù hợp" nhằm đảm bảo an toàn cho nhân viên y tế và những người có nguy cơ lây nhiễm cao. WHO cũng kêu gọi các quốc gia nằm trong vùng dịch tăng cường các biện pháp phòng chống, đồng thời sẵn sàng đối phó với nguy cơ lây nhiễm, thông qua việc tăng cường huấn luyện và đào tạo nhân viên y tế.
 |
| Lệnh giới nghiêm do dịch bệnh Ebola được ban bố ở Liberia |
Tổng thống Liberia Ellen Johnson Sirleaf đã ban bố lệnh giới nghiêm vào ban đêm tại thủ đô Monrovia từ ngày 20/8 và tiến hành cách ly những khu vực bị ảnh hưởng nhằm ngăn chặn dịch bệnh Ebola lan rộng. Lệnh của Tổng thống Sirleaf được đưa ra sau khi Liberia ghi nhận số người mới tử vong vì Ebola đạt mức kỷ lục (53 người), nhiều hơn tại Sierra Leone (17 người) và Guinea (14 người). Trong một phát biểu trên đài phát thanh tối 19/8, Tổng thống Sirleaf cho biết lệnh giới nghiêm sẽ bắt đầu từ 21h00 đến 6h00 hàng ngày và mọi trung tâm giải trí đều phải đóng cửa từ 18h00. Theo lệnh của tổng thống, trong số các khu vực mới được cách ly có khu nhà ổ chuột West Point ở thủ đô Monrovia. Tổng thống cũng cảnh báo các phong tục địa phương là một trong số các tác nhân lây nhiễm dịch bệnh. Cùng ngày, Bộ trưởng Thông tin Liberia Lewis Brown đã thông báo sự trở về của 17 bệnh nhân nhiễm virus Ebola bị cưỡng ép rời khỏi một trung tâm y tế ở West Point hôm 16/8 sau khi trung tâm bị tấn công. Sự mất tích của họ trong những ngày qua đã làm dấy lên mối lo ngại một kịch bản ác mộng về khả năng lây nhiễm cao khắp thủ đô. Bộ trưởng Brown cho biết thêm một lực lượng phản ứng nhanh đã được thành lập để đến tận từng nhà tại West Point giải thích nguy cơ mắc bệnh cũng như sự cần thiết phải cách ly những người đã nhiễm virus.
 |
| Thành phố trở nên hoang tàn do dịch bệnh Ebola |
Bộ trưởng Brown cũng thông báo ba nhân viên y tế châu Phi được dùng thuốc ZMapp đã có "dấu hiệu cải thiện đáng kể". ZMap là thuốc chưa qua thử nghiệm lâm sàng trên người bệnh, nhưng đã được WHO cho phép sử dụng trong bối cảnh dịch Ebola đang lan rộng và đã cướp đi sinh mạng của 1.229 người, chiếm 90% số người bị nhiễm. ZMapp là loại huyết thanh gồm 3 kháng thể này được điều chế từ lá cây thuốc lá đã biến đổi gien. Loại thuốc này đã được sử dụng cho hai nhân viên của tổ chức phi chính phủ "Samaritan's Purse" (Mỹ) bị nhiễm virus Ebola tại Liberia. Cả hai người này có phản ứng tốt với ZMapp. Tuy nhiên, một bệnh nhân khác là nhà truyền giáo người Tây Ban Nha cũng được sử dụng loại thuốc này đã tử vong tại một bệnh viên ở Madrid. Hãng dược phẩm Mapp Bioparmaceutical của Mỹ bào chế ra loại thuốc trên cho biết họ đã gửi toàn bộ số thuốc có sẵn đến Tây Phi. Theo tin mới nhất, tại Nigeria, một bác sĩ từng điều trị cho bệnh nhân đầu tiên nhiễm virus Ebola ở nước này đã qua đời, đó là bác sĩ Patrick Sawyer, 40 tuổi, người Mỹ gốc Liberia. Theo Bộ trưởng Y tế Nigeria onyebuchi Chukwu, tổng số ca tử vong vì Ebola ở quốc gia đông dân nhất châu Phi này tính đến ngày 19/8 là 5 người. Tuy nhiên người phát ngôn của WHO Fadela Chaib đã ghi nhận "những dấu hiệu đáng khích lệ" tại Nigeria và tại Guinea, nơi các biện pháp đề phòng cũng như nỗ lực truy tìm các con đường lây nhiễm đã bắt đầu phát huy tác dụng.
Theo kế hoạch, đặc phái viên Liên hợp quốc (LHQ) về Ebola, chuyên gia vật lý người Anh David Nabarro sẽ tới khu vực Tây Phi trong ngày 20/8 nhằm tăng cường các dịch vụ y tế tại 4 quốc gia có người nhiễm loại virus chết người này. Ông Nabarro sẽ đi cùng một chuyên gia của WHO là Keiji Fukuda. Chuyến công du sẽ tập trung "vực dậy lĩnh vực y tế" tại các quốc gia Tây Phi, nơi các cơ quan y tế công cộng vừa phải đấu tranh chống lại các bệnh gây chết người hàng loạt như sốt rét, trong khi một số nước vừa thoát khỏi nhiều năm bị tàn phá bởi xung đột, chiến tranh. Cùng ngày, WHO ra tuyên bố cho biết tổ chức này đang phối hợp với Tổ chức nông lương Liên hiệp quốc (FAO) để phân phát thực phẩm cho khoảng một triệu người đang sống trong các vùng bị cách ly vì Ebola ở khu vực biên giới giữa ba nước Guinea, Liberia và Sierra Leone.
|
| Các nhà khoa học theo dõi EVD đột biến gen tại phòng thí nghiệm |
Trong khi đó, giới khoa học đang theo dõi chặt chẽ hiện tượng đột biến gen của loại virus nguy hiểm này. Giám đốc Trung tâm Nghiên cứu và Chính sách đối với các bệnh truyền nhiễm tại Đại học Minnesota (Mỹ), ông Michael Osterholm cũng bày tỏ lo ngại về việc virus này có khả năng lây nhiễm qua không khí giống như bệnh cúm và có thể gây tử vong trên quy mô lớn. Giám đốc Viện Dị ứng và Bệnh truyền nhiễm quốc gia của Mỹ, ông Anthony Fauci cũng cho rằng khả năng virus Ebola phát tán trong không khí là có thể, tuy nhiên nguy cơ này không cao.
 |
| Chuyên gia Trung Quốc huấn luyện nhân viên y tế Tây Phi chống dịch Ebola |
Liên quan đến nỗ lực chung nhằm ngăn chặn dịch bệnh gây chết người này, ngày 22/9, Đại sứ Trung Quốc tại Sierra Leone, ông Zhao Yanbo tái khẳng định cam kết của Bắc Kinh hỗ trợ Sierra Leone kiếm soát dịch Ebola. Ông Zhao Yanbo cho biết Nhóm nhân viên y tế Trung Quốc được điều tới Sierra Leone sẽ giúp lập một mạng lưới y tế cần thiết nhằm xử lý tình huống xấu nhất có thể xảy ra. Hiện Trung Quốc đã đưa 29 chuyên gia thuộc các phòng thí nghiệm và 30 chuyên gia hỗ trợ y tế thuộc Trung tâm phòng chống và kiểm soát bệnh và các bệnh viện lớn của Trung Quốc đến Sierra Leone để giúp triển khai kế hoạch.